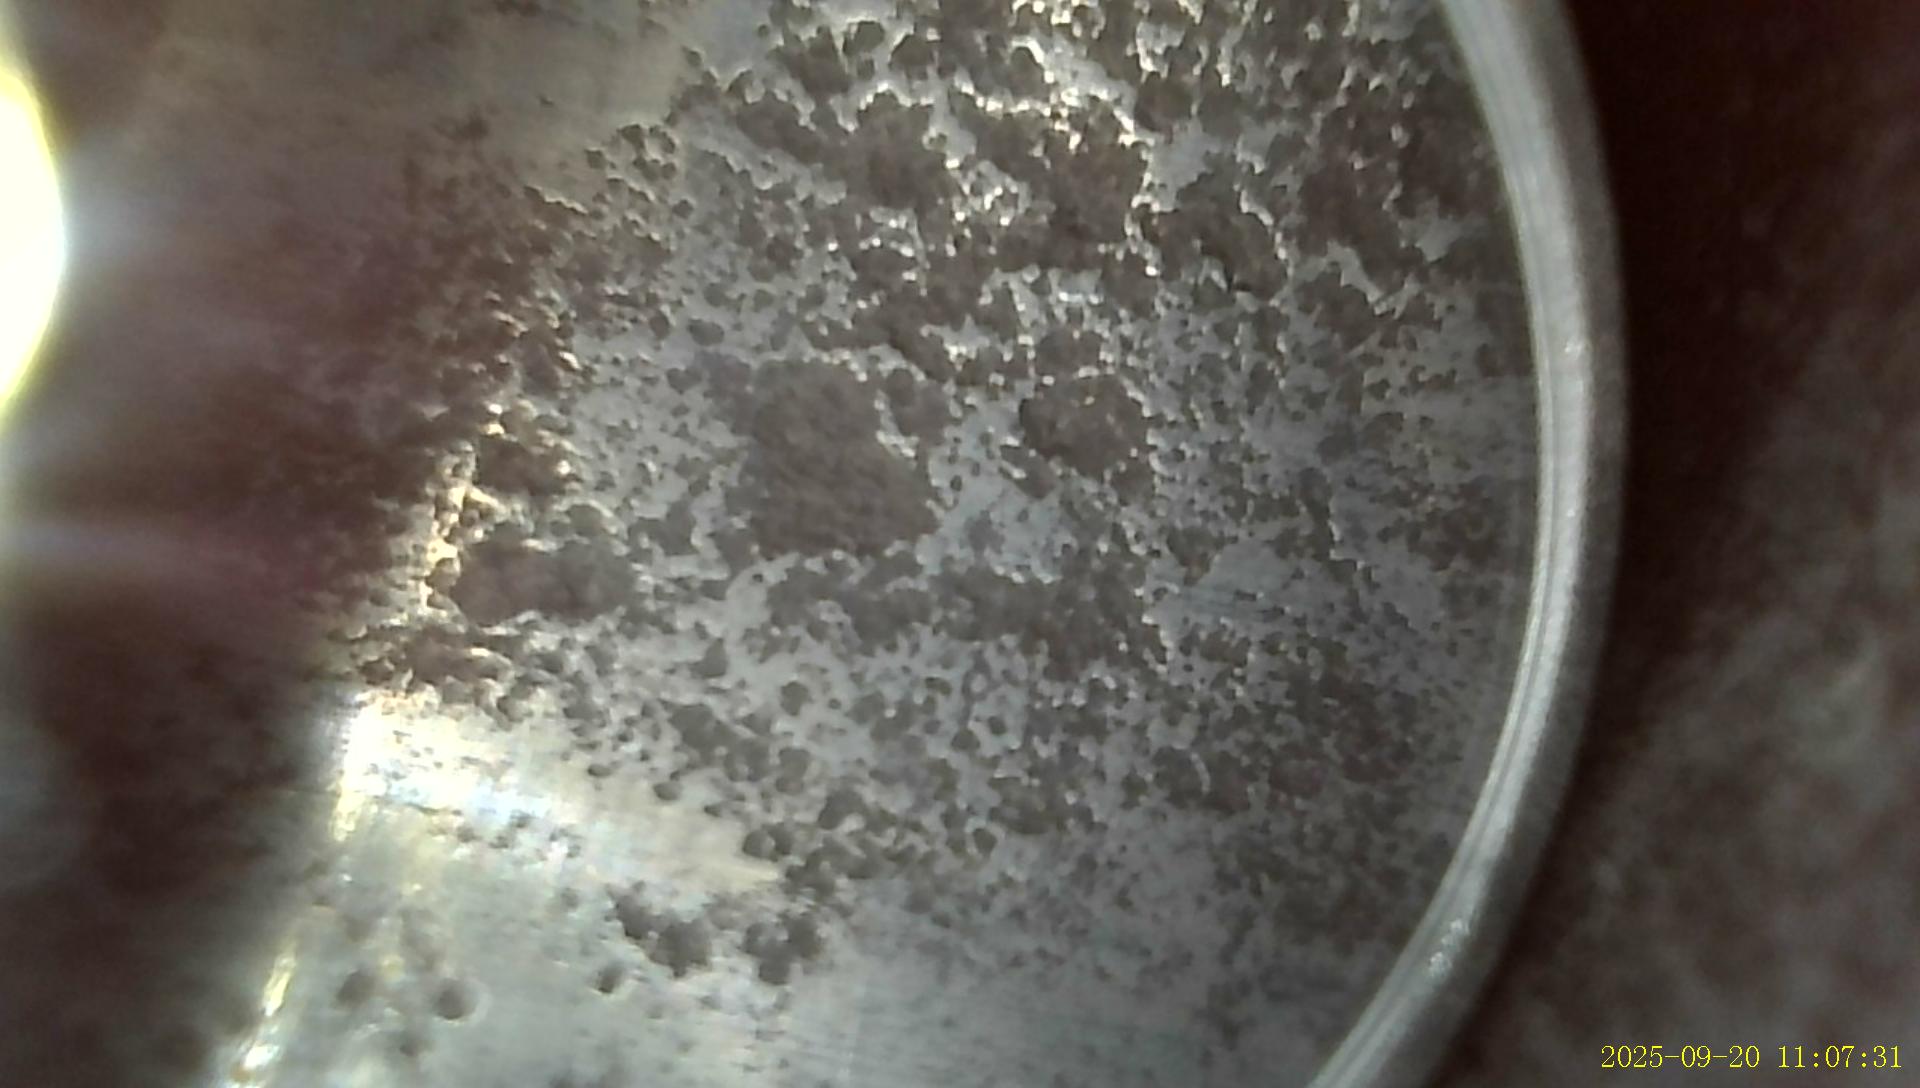
Post header image

Συντήρηση και Ζημιές Κάννων Κυνηγετικού Όπλου
Του Κώστα Πελετιέ
Διπλωματούχου Οπλουργού Αμερικής
Το κυνήγι πλησιάζει και πάλι, και όπως κάθε φθινόπωρο, οι περισσότεροι από εμάς θα βγάλουμε από το ντουλάπι το κυνηγετικό μας όπλο, τον πιστό σύντροφο σε στιγμές χαράς και συγκίνησης. Συνήθως, η προσοχή μας επικεντρώνεται στην εξωτερική του εμφάνιση· θέλουμε το όπλο να δείχνει καθαρό και φροντισμένο. Όμως, η ουσία κρύβεται βαθύτερα, μέσα στην καρδιά του: στην κάννη. Εκεί όπου γεννιέται η βολή, εκεί όπου η δύναμη του φυσιγγίου μετατρέπεται σε κίνηση και ακρίβεια.
Τι είναι η κάννη;
Η κάννη δεν είναι απλώς ένα κομμάτι μετάλλου. Είναι η διαδρομή του βλήματος, ο διάδρομος από τη θαλάμη – όπου τοποθετούμε το φυσίγγι – έως την έξοδο. Στα λειόκαννα δεν υπάρχουν ραβδώσεις, όπως στα ραβδωτά όπλα, αλλά συναντούμε συχνά το choke: μια διαμόρφωση στο άκρο της κάννης που ρυθμίζει τη διασπορά των σκαγιών. Στα σύγχρονα όπλα μπορεί να είναι σταθερό ή εναλλάξιμο, προσφέροντας στον κυνηγό ευελιξία ανάλογα με το θήραμα.
Γιατί είναι σημαντική η συντήρηση;
Η κάννη είναι το πιο δοκιμαζόμενο μέρος του όπλου. Αν την αφήσουμε στην τύχη της, η διάβρωση, τα υπολείμματα πυρίτιδας και οι κακουχίες του κυνηγιού θα τη φθείρουν, μειώνοντας την ακρίβεια και – σε ακραίες περιπτώσεις – θέτοντας σε κίνδυνο την ασφάλειά μας. Η σωστή συντήρηση δεν είναι τυπική αγγαρεία· είναι η εγγύηση ότι το όπλο μας θα ανταποκριθεί όταν το χρειαστούμε.
Πώς φροντίζουμε την κάννη
Πρώτα απ’ όλα, υπενθύμιση: πριν αγγίξουμε το όπλο για καθαρισμό, βεβαιωνόμαστε πως είναι άδειο, χωρίς φυσίγγια στη θαλάμη.
Καθαρισμός μετά από κάθε χρήση: Με μια βούρτσα (κατά προτίμηση από μπρούντζο) ή σχοινί καθαρισμού και ειδικό υγρό (solvent), περνάμε την κάννη αρκετές φορές ώσπου τα πανιά να βγαίνουν καθαρά. Έτσι απομακρύνουμε τα κατάλοιπα πυρίτιδας και σκαγιών.
Έλεγχος για εμπόδια: Μικρά χαλίκια, χώμα ή κομμάτια από βύσματα μπορούν να μετατραπούν σε θανάσιμη παγίδα αν μείνουν μέσα στην κάννη. Ένας γρήγορος οπτικός έλεγχος πριν από κάθε έξοδο είναι απαραίτητος.
Στέγνωμα και λίπανση: Αφού καθαρίσουμε, σκουπίζουμε καλά και περνάμε μια ελαφριά στρώση αντιδιαβρωτικού λαδιού, μέσα κι έξω. Προσοχή στην υπερβολή: πολύ λάδι τραβά σκόνη και δημιουργεί νέα προβλήματα. Πριν από κάθε χρήση του όπλου φροντίζουμε να αφαιρέσουμε εσωτερικά το λάδι από τις κάννες.
Έλεγχος choke: Αν το όπλο διαθέτει εναλλάξιμα chokes, φροντίζουμε να καθαρίζουμε τα σπειρώματα και να ελέγχουμε για σκουριά ή φθορά και προσθέτουμε ειδικό γράσο προστασίας από την σκουριά .
Φροντίδα εξωτερικής επιφάνειας: Ένα απλό σκούπισμα μετά από επαφή με ιδρώτα ή υγρασία προστατεύει το μέταλλο από τη σκουριά.
Επαγγελματικός έλεγχος: Κάθε λίγα χρόνια, ένας οπλουργός μπορεί να δει με ειδικά όργανα φθορές που το μάτι μας δεν πιάνει. Η επίσκεψη αυτή είναι μια επένδυση στην ασφάλεια.
Ζημιές από αμέλεια
Σκουριά και διάβρωση: Το μεγαλύτερο εχθρό της κάννης τον φέρνει η υγρασία και τα κατάλοιπα πυρίτιδας. Η διάβρωση ξεκινά ως μικρές κηλίδες και καταλήγει σε κοιλότητες (pitting) που αλλοιώνουν τη βολή.
Erosion: Η παρατεταμένη χρήση με σκληρά φυσίγγια μπορεί να φθείρει την έξοδο της κάννης και το choke.
Καταπόνηση υλικού: Χτυπήματα, πτώσεις ή υπερβολική χρήση χωρίς φροντίδα μπορεί να προκαλέσουν ρωγμές ή παραμορφώσεις.
Εμπλοκές: Ξένα σώματα μέσα στην κάννη είναι η πιο επικίνδυνη μορφή αμέλειας· μπορούν να οδηγήσουν σε διάρρηξη της κάννης.
Σημάδια κινδύνου
Αν η διασπορά των σκαγιών γίνεται υπερβολικά πλατιά, αν ακούτε περίεργους ήχους, αν βλέπετε σκουριά ή κοιλότητες στο εσωτερικό, σταματήστε αμέσως τη χρήση. Ο οπλουργός είναι ο μόνος που μπορεί να κρίνει αν η κάννη παραμένει ασφαλής.
Πρόληψη και αποθήκευση
Η φροντίδα δεν τελειώνει με τον καθαρισμό. Η σωστή αποθήκευση είναι το επόμενο βήμα:
Φυλάσσουμε το όπλο σε δροσερό, ξηρό μέρος, μακριά από υγρασία.
Προτιμούμε θήκες με αντιδιαβρωτικά υλικά. Η θήκη που φυλάσσουμε το όπλο θα είναι άλλη από την θήκη μεταφοράς
Αποφεύγουμε υπόγεια ή χώρους με έντονες αλλαγές θερμοκρασίας.
Το όπλο μας δεν είναι απλώς ένα εργαλείο. Είναι κομμάτι της κυνηγετικής μας ταυτότητας, μάρτυρας εμπειριών και αναμνήσεων. Η κάννη του, αυτός ο ατσάλινος σωλήνας, αξίζει τη φροντίδα μας. Με λίγη προσοχή και συνέπεια, θα συνεχίσει να μας συντροφεύει για πολλά χρόνια, με ασφάλεια και αξιοπιστία.








